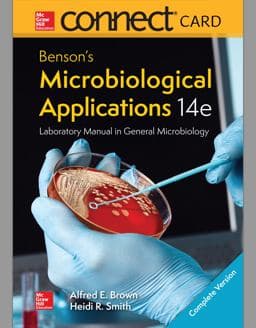
9781259919817

Connect Access Card for Benson's Microbiology Applications Complete Version
Format:
ISBN13: 9781259919817
|9781259919817
Out of Stock
Overview
McGraw-Hill Connect® is a subscription-based learning service accessible online through your personal computer or tablet. Choose this option if your instructor will require Connect to be used in the course. Your subscription to Connect includes the following:
* A digital version of the course textbook that saves you time while improving performance.
* Access to your instructor's homework assignments, quizzes, syllabus, notes, reminders, and other important files for the course.
* Progress dashboards that quickly show how you are performing on your assignments and tips for improvement.
* The option to purchase (for a small fee) a print version of the book. This binder-ready, loose-leaf version includes free shipping.
Complete system requirements to use Connect can be found here: http://www.mheducation.com/highered/platforms/connect/training-support-students.html
* A digital version of the course textbook that saves you time while improving performance.
* Access to your instructor's homework assignments, quizzes, syllabus, notes, reminders, and other important files for the course.
* Progress dashboards that quickly show how you are performing on your assignments and tips for improvement.
* The option to purchase (for a small fee) a print version of the book. This binder-ready, loose-leaf version includes free shipping.
Complete system requirements to use Connect can be found here: http://www.mheducation.com/highered/platforms/connect/training-support-students.html
| ISBN-13 | 9781259919817 |
|---|---|
| ISBN-10 | 1259919811 |
| Weight | 0.01 Pounds |
| Dimensions | 0.80 x 0.01 x 0.50 In |
| List Price | $136.99 |
| Edition | 14th Edition |
| Format | - |
|---|---|
| Publisher | McGraw-Hill |
| Published On | 2016-09-27 |
View All Offers
Sort by:
Price